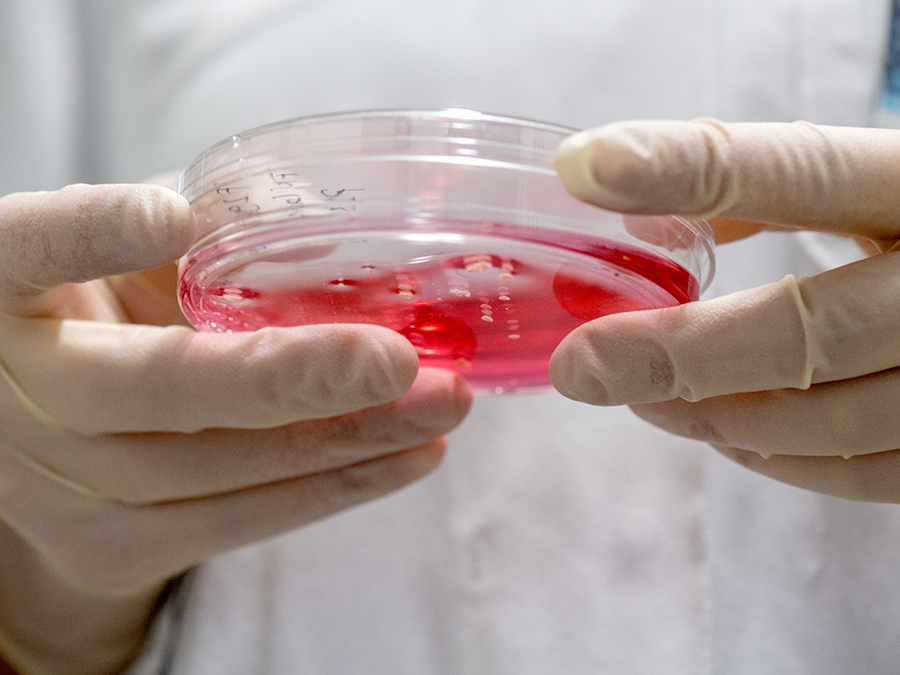
Arbeiten mit Zellkulturen sind in der onkologischen Grundlagenforschung ein wichtiges Werkzeug. (Bild: A. Heddergott / TUM)

Tumorforschung erhält Förderung der DFG
Zwei neue Sonderforschungsbereiche an der TUM
Prof. Jürgen Ruland, Professor für Klinische Chemie und Pathobiochemie an der TUM, ist Sprecher des neuen SFBs „Aberrante Immunsignale bei Krebserkrankungen“. Ziel dieses Gemeinschaftsprojekts ist es, fehlgeleitete Signale im Immunsystem zu analysieren, die die Krebsentstehung begünstigen oder die Tumorabwehr unterdrücken. Damit sollen grundlegende und übergeordnete Mechanismen verschiedenster Tumorarten erforscht werden. Das wissenschaftliche Team will neue Erkenntnisse zum molekularen Verständnis pathogener Immunsignale bei Tumorerkrankungen liefern und neue Strategien für deren gezielte Manipulation zur Krebstherapie aufzeigen.
Neben der TUM sind die Ludwig-Maximilians-Universität München (LMU), das Helmholtz Zentrum München (HMGU), das Max-Planck-Institut für Biochemie und das Deutsche Krebsforschungszentrum (DKFZ) am Projekt beteiligt.
Bauchspeicheldrüsenkrebs im Fokus
Einer sehr aggressiven und schwer therapierbaren Krebsform widmet sich der neue SFB „Modellierung und Targeting des Pankreaskarzinoms“. Der Sprecher Prof. Roland M. Schmid, Direktor der Klinik und Poliklinik für Innere Medizin II am Klinikum rechts der Isar, untersucht darin mit seinem Projektteam die biologischen Eigenschaften des Bauchspeicheldrüsenkrebses. Die Forscherinnen und Forscher gehen davon aus, dass nur ein umfassendes mechanistisches Verständnis des Pankreaskarzinoms mit seinen extremen und einzigartigen Eigenschaften zu einer nachhaltigen Verbesserung der Prognose der betroffenen Patienten führen wird. Mit einer klinischen Ausrichtung will der SFB künftig die Therapiemöglichkeiten dieser Krebsform verbessern.
Partner im neuen SFB sind außerdem die Ludwig-Maximilians-Universität München (LMU) und das Helmholtz Zentrum München (HMGU).
Wie entstand das Leben?
Die TUM ist zudem mit acht Arbeitsgruppen in einem weiteren neuen SFB vertreten. Ziel der Forschung des überregionalen Sonderforschungsbereichs „Lebensentstehung: Erkundung von Mechanismen mit interdisziplinären Experimenten“ ist es, unterschiedliche Hypothesen über die Entstehung des Lebens im Labor zu testen. Ermöglicht wird dies durch die enge Zusammenarbeit von Wissenschaftlerinnen und Wissenschaftlern der Astronomie, Biologie, Chemie, Geowissenschaften und Physik.
Sprecher ist Prof. Dieter Braun (Ludwig Maximilians-Universität München). Weitere Kooperationspartner sind das Max-Planck-Institut für extraterrestrische Physik in Garching, das Max-Planck-Institut für Biochemie in Martinsried und das Helmholtz Zentrum München, die Universität Stuttgart und die Universität Heidelberg.
Weitere SFBs mit TUM-Beteiligung verlängert
Außerdem entschied die DFG über die Verlängerung bereits laufender Sonderforschungsbereiche. Unter den 21 verlängerten Projekten ist die TUM mit den überregionalen Sonderforschungsbereichen „ Invasives Rechnen“ (TRR 89, Informatik) und „Steuerung der Körperhomöostase durch TRP-Kanal-Module“ (TRR 152, Medizin) sowie dem SFB „Atherosklerose: Mechanismen und Netzwerke neuer therapeutischer Zielstrukturen“ (SFB 1123, Medizin) dreimal vertreten.
Die Sonderforschungsbereiche der DFG gehören zu den wichtigsten Forschungsförderprogrammen Deutschlands. Sie unterstützt anspruchsvolle, interdisziplinäre und langfristig angelegte Forschungsvorhaben. Die DFG bewilligt sie zunächst für vier Jahre, insgesamt können sie zwölf Jahre lang gefördert werden.
Mehr InformationEN:
Technische Universität München
Corporate Communications Center
- Dr. Vera Siegler
- vera.siegler@tum.de
- presse@tum.de
- Teamwebsite


